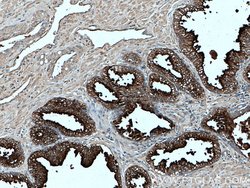
PSMA/GCPII Mouse anti-Human, Rat, Clone: 3G4E12, Proteintech 20 &mu;L;

missing translation for 'onlineSavingsMsg'
Learn More
Learn More
PSMA/GCPII Mouse anti-Human, Rat, Clone: 3G4E12, Proteintech
Mouse Monoclonal Antibody
Brand: Proteintech 66678-1-IG-20UL
This item is not returnable.
View return policy
Description
PMSA (FOLH1) is a type II transmembrane glycoprotein belonging to the M28 peptidase family. Three functionally distinct proteins are encoded, including folylpoly-gamma-glutamate carboxypeptidase in the intestine, N-acetylated alpha-linked acidic dipeptidase 1 in the brain, and prostate-specific membrane antigen in the prostate. A mutation in the intestinal form may be associated with impaired intestinal absorption of dietary folates, resulting in low blood folate levels and consequent hyperhomocysteinemia. The form expressed in the brain may be involved in a number of pathological conditions associated with glutamate excitotoxicity. The prostate form is up-regulated in cancerous cells and is used as an effective diagnostic and prognostic indicator of prostate cancer. This gene likely arose from a duplication event of a nearby chromosomal region.Specifications
| PSMA/GCPII | |
| Monoclonal | |
| 1 mg/mL | |
| PBS with 50% glycerol and 0.1% sodium azide; pH 7.3 | |
| P70627, Q04609 | |
| Folh1 | |
| PSMA/GCPII Fusion Protein Ag16594 | |
| 20 μL | |
| Primary | |
| Human, Rat | |
| Antibody | |
| IgG1 |
| Immunohistochemistry (Paraffin), Western Blot | |
| 3G4E12 | |
| Unconjugated | |
| FOLH1 | |
| FGCP, Folate hydrolase 1, FOLH, FOLH1, GCP2, GCPII, Glutamate carboxypeptidase 2, Glutamate carboxypeptidase II, mGCP, NAALAD1, NAALAdase, NAALADase I, PSM, PSMA | |
| Mouse | |
| Protein G | |
| RUO | |
| 2346, 85309 | |
| -20°C | |
| Liquid |
Korrektion af produktindhold
Dit input er vigtigt for os. Udfyld denne formular for at give feedback relateret til indholdet på dette produkt.
Produkttitel
Ser du en mulighed for forbedring?Del en indholdskorrektion